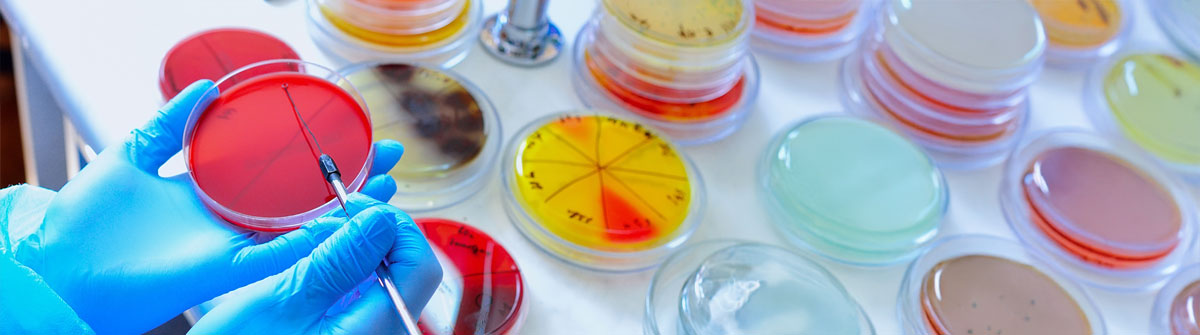
Werte Darm-Mikrobiom Analyse

Laborwerte verstehen – Ihr Weg zu mehr Gesundheit
Laborwerte liefern wertvolle Informationen über Ihren Gesundheitszustand und helfen, mögliche Ungleichgewichte oder Mangelzustände frühzeitig zu erkennen. Doch was bedeuten die Zahlen und Werte im Laborbefund? Auf dieser Seite erfahren Sie, wie Sie Ihre Laborergebnisse besser verstehen und einordnen können.
Warum sind Laborwerte wichtig?
Laboranalysen sind ein wesentlicher Bestandteil der Gesundheitsvorsorge. Sie ermöglichen es, Beschwerden gezielt auf den Grund zu gehen, Mangelzustände oder Überlastungen frühzeitig zu erkennen und individuelle Maßnahmen zur Gesundheitsoptimierung einzuleiten. Viele Erkrankungen hinterlassen messbare Spuren im Körper.
Labortests liefern wertvolle Hinweise auf gesundheitliche Auffälligkeiten, helfen bei der Einordnung von Symptomen und ermöglichen eine frühzeitige Risikoerkennung. Da zahlreiche Gesundheitsprobleme äußerlich nicht sofort sichtbar sind, spielen Laboruntersuchungen eine zentrale Rolle in der modernen Diagnostik.
Gut zu wissen!
Wussten Sie, dass jedes Labor seine eigenen Messgeräte und Messmethoden verwendet? Daher können die Ergebnisse von Labor zu Labor variieren. Um die Werte korrekt zu interpretieren, ist es wichtig, dass auf dem Befund die Referenzbereiche des jeweiligen Labors angegeben sind.
So interpretieren Sie Ihre Laborwerte richtig
Jeder Laborwert bewegt sich innerhalb eines bestimmten Referenzbereichs. Doch was bedeutet das?
- Referenzwerte: Sie geben den Bereich an, in dem ein Wert als „normal“ gilt. Abweichungen bedeuten nicht immer eine Krankheit, sondern können auch durch Ernährung, Stress oder andere Faktoren beeinflusst sein.
- Erhöhte oder erniedrigte Werte: Diese können auf einen Mangel oder eine Belastung hinweisen und sollten im Gesamtbild betrachtet werden.
- Individuelle Faktoren: Alter, Geschlecht, Lebensstil und Vorerkrankungen können die Laborwerte beeinflussen.

Was tun bei auffälligen Werten?
- Prüfen Sie, ob Faktoren wie Ernährung oder Stress Ihre Werte beeinflusst haben.
- Wiederholen Sie die Messung nach einiger Zeit, um Veränderungen nachzuverfolgen.
- Nutzen Sie die Ergebnisse als Gesprächsgrundlage für eine weiterführende Beratung bei Ihrem Arzt, Heilpraktiker oder Apotheker.
Warum weichen meine Werte von den Referenzbereichen ab?
Jeder Mensch ist individuell. Referenzwerte sind Durchschnittswerte, doch persönliche Faktoren wie Ernährung, Lebensstil oder Vorerkrankungen können dazu führen, dass Ihre Werte außerhalb des Normbereichs liegen, ohne dass dies sofort besorgniserregend ist. Allerdings gibt es auch Werte die medizinisch abgeklärt werden sollten.
Wie oft sollte ich meine Werte überprüfen lassen?
Das hängt von Ihrem Gesundheitszustand ab. Bestimmte Werte, wie z. B. Vitamin D oder Eisen, sollten regelmäßig kontrolliert werden, insbesondere wenn Mangelerscheinungen auftreten oder ein erhöhtes Risiko besteht. Für medizinisch relevante Werte wie z.B. Cholesterin gilt: Falls Auffälligkeiten vorliegen oder Risikofaktoren bestehen, ist eine regelmäßige Kontrolle sinnvoll. In diesen Fällen kann Ihr Arzt oder Therapeut Sie individuell beraten.
Was mache ich mit meinem Laborbefund?
Nutzen Sie die Ergebnisse, um gezielt Maßnahmen für Ihre Gesundheit zu ergreifen. Eine ärztliche Beratung kann sinnvoll sein, wenn auffällige Werte oder bestehende Beschwerden vorliegen. Bei unseren Gesundheitsexperten können Sie einen Therapeuten finden, der Ihnen weiterhelfen kann.
Mit den medivere-Gesundheitstests erhalten Sie eine wissenschaftlich fundierte Analyse, die Ihnen hilft, Ihre Gesundheit besser zu verstehen und aktiv zu verbessern.
Warum ergab die Analyse bei meinem Arzt andere Ergebnisse?
Unterschiede zwischen den Laborergebnissen beim Arzt und den Ergebnissen unserer medivere-Gesundheitstests können verschiedene Ursachen haben. Hier sind die häufigsten Gründe:
- Unterschiedliche Probenarten und Präanalytik
Beim Arzt erfolgt die Blutentnahme meist aus der Armvene (venöses Blut), während unsere Selbsttests Kapillarblut aus der Fingerkuppe nutzen. Die Analyse findet in denselben Fachlaboren statt, die auch Ärzte verwenden, sodass die Ergebnisse grundsätzlich vergleichbar sind. Unterschiede können jedoch durch die Probennahme entstehen. Unsere Kapillarbluttests sind sorgfältig validiert, um die gleichwertige Aussagekraft wie venöses Blut zu gewährleisten. Allerdings kann eine unsachgemäße Entnahme, wie starkes Quetschen des Fingers, die Messwerte beeinflussen. Ebenso kann eine zu lange Stauung des Arms bei einer venösen Blutentnahme die Blutwerte verändern. - Zeitpunkt der Probenentnahme
Laborwerte sind oft tageszeitabhängig. Beispielsweise schwanken Hormonspiegel (z. B. Cortisol oder Testosteron) im Tagesverlauf stark. Wird die Probe zu einem anderen Zeitpunkt als beim Arzt entnommen, kann dies zu abweichenden Werten führen. - Einfluss externer Faktoren
Ernährung, Stress, Medikamente oder sportliche Aktivität vor der Probenentnahme können die Werte beeinflussen. Ein nüchtern entnommener Blutwert kann sich von einem Wert unterscheiden, der nach dem Essen bestimmt wurde. - Analysenmethode und Referenzbereiche
Laborwerte werden mit unterschiedlichen Messmethoden und Analysegeräten bestimmt. Jedes Labor hat eigene Referenzwerte, die leicht abweichen können. Dies bedeutet nicht, dass ein Ergebnis falsch ist – es basiert lediglich auf einer anderen Messgrundlage. Die Grundaussage sollte aber gleich sein. - Transport und Lagerung
Lagerung und der Transport ins Labor können Einfluss auf bestimmte Werte haben. Auch bei einer Probenentnahme unter optimalen Bedingungen, können Lagerdauer und Temperatur der Probe eine Rolle spielen können. - Individuelle Schwankungen
Laborwerte sind keine statischen Größen. Sie können durch viele Faktoren beeinflusst werden, z. B. Flüssigkeitsaufnahme, Mahlzeiten, Hormonzyklen oder körperliche Belastung. Daher ist es sinnvoll, Werte im Verlauf zu betrachten und nicht isoliert zu bewerten.
Fazit:
Unterschiede zwischen Laborergebnissen sind normal und bedeuten nicht zwangsläufig, dass ein Ergebnis falsch ist. Wichtig ist, die Werte immer im Gesamtbild zu betrachten und sich bei Unklarheiten mit einem Arzt oder Therapeuten zu besprechen.

Was sind die wichtigsten Blutwerte?
Die wichtigsten Blutwerte geben Auskunft über Ihre Gesundheit und können auf mögliche Erkrankungen hinweisen. Hier sind die zentralen Werte und ihre Bedeutung:
- Blutbild & Blutzellen
> Hämoglobin (Hb) – Gibt den Sauerstoffgehalt des Blutes an. Niedrige Werte können auf eine Anämie hindeuten.
> Hämatokrit (Hkt) – Zeigt den Anteil der Blutzellen am Gesamtblutvolumen. Besonders bei Vollblutanalysen von Mikronährstoffen (z. B. Zink, Magnesium) ist der Hämatokritwert entscheidend, da er eine genauere Beurteilung und Anpassung der Referenzwerte ermöglicht.
> Erythrozyten (rote Blutkörperchen) – Wichtig für den Sauerstofftransport.
> Leukozyten (weiße Blutkörperchen) – Wichtige Abwehrzellen des Immunsystems, erhöhter Wert kann z.B. auf eine Infektion hinweisen.
> Thrombozyten (Blutplättchen) – Zuständig für die Blutgerinnung. - Entzündungs- & Infektionswerte
> CRP (C-reaktives Protein) – Erhöhter Wert deutet auf Entzündungen oder Infektionen hin.
> BSG (Blutsenkungsgeschwindigkeit) – Gibt Hinweise auf chronische Entzündungen. - Leberwerte
> GOT (AST), GPT (ALT), Gamma-GT – Enzyme, die auf eine Lebererkrankung oder Leberschäden hinweisen können.
> Bilirubin – Wichtig für die Diagnose von Gelbsucht und Leberfunktion. - Nierenwerte
> Kreatinin – Ein Abfallprodukt des Muskelstoffwechsels, erhöht bei Nierenproblemen.
> Harnstoff & Harnsäure – Zeigen an, wie gut die Nieren Abfallprodukte ausscheiden. - Blutfette (Cholesterin & Triglyceride)
> Gesamtcholesterin – Wichtiger Baustein im Körper, aber zu hohe Werte erhöhen das Risiko für Herz-Kreislauf-Erkrankungen.
> LDL-Cholesterin (schlechtes Cholesterin) – Fördert Arterienverkalkung.
> LDL-Typ 1-2 – Größere Partikel, weniger schädlich.
> LDL-Typ 3-7 – Kleiner, dichte Partikel, höheres Risiko.
> HDL-Cholesterin (gutes Cholesterin, wenn es nicht zu hoch wird) – Schützt die Gefäße.
> Triglyceride – Energiespeicher des Körpers. Wichtige Blutfette, die bei Übergewicht oder Diabetes erhöht sein können. Dauerhaft hohe Werte können das Risiko für Fettstoffwechselerkrankungen erhöhen. - Zuckerstoffwechsel & Diabetes
> Glukose (Blutzucker) – Zeigt das Diabetes-Risiko an.
> HbA1c (Langzeitblutzucker) – Gibt den durchschnittlichen Blutzuckerwert der letzten Wochen wieder. - Mineralstoffe & Vitamine
> Eisen – Wichtig für den Sauerstofftransport im Blut, beugt Müdigkeit vor
> Kupfer – Unterstützt den Eisenstoffwechsel und das Immunsystem
> Magnesium – Wichtig für Muskeln, Nerven und Energieproduktion
> Selen – Unterstützt die Schilddrüse und schützt die Zellen
> Zink – Stärkt das Immunsystem, fördert Wundheilung und Hautgesundheit
> Mangan – Wichtig für Knochen, Bindegewebe und Stoffwechsel
> Molybdän – Unterstützt die Entgiftung
> Vitamin B6 – Unterstützt Nerven, Hormonhaushalt und Eiweißstoffwechsel
> Vitamin B12 – Wichtig für Nerven, Blutbildung und Energie
> Vitamin D – Stärkt Knochen, Immunsystem und trägt zur Stimmung bei. - Hormonwerte
> TSH (Schilddrüsenstimulierendes Hormon) – Gibt Hinweise auf eine Schilddrüsenunter- oder -überfunktion.
> fT3, fT4 (freie Schilddrüsenhormone) – Ergänzende Werte zur Schilddrüsendiagnostik.
> Cortisol – Stresshormon, beeinflusst den Stoffwechsel und das Immunsystem. Abweichungen können auf akuten oder chronischen Stress oder eine Nebennierenschwäche hinweisen.
> Geschlechtshormone (Östrogen, Progesteron, Testosteron) – Die frei verfügbaren Hormone, die aktiv im Körper wirken, können bei hormonellen Dysbalancen wie PMS, Wechseljahresbeschwerden oder Libidoverlust hilfreich sein.
> DHEA – Das Vorläuferhormon als natürlicher Gegenspieler von Cortisol spielt eine wichtige Rolle. DHEA wird oft mit Vitalität, Anti-Aging und Regeneration in Verbindunggebracht, da es die Produktion von Geschlechtshormonen unterstützt und mit stetigem Alter natürlicherweise abnimmt.
> Melatonin – Verantwortlich für den Schlaf-Wach-Rhythmus.
Welche Werte sind für die Darmgesundheit wichtig?
Die Analyse des Darm-Mikrobioms und der damit verbundenen Marker liefert wichtige Werte, die Hinweise auf die Darmgesundheit, das Gleichgewicht der Darmflora, die Barrierefunktion der Darmschleimhaut sowie mögliche entzündliche Prozesse. Folgende Parameter sind besonders relevant:
- Bakterielle Vielfalt & Zusammensetzung
> Mikrobiologische/ molekularbiologische Analyse – Untersuchung aerober und anaerober Leitkeime, um die Zusammensetzung der Darmflora zu bewerten. Ein Ungleichgewicht kann Hinweise auf Dysbiose oder Veränderungen der Verdauung geben. Ein Ungleichgewicht in Richtung Firmicutes wird mit Gewichtszunahme in Verbindung gebracht.
> Firmicutes/Bacteroidetes-Verhältnis – Diese beiden Bakteriengruppen dominieren das Mikrobiom. Ein Ungleichgewicht kann auf Stoffwechselprobleme oder eine veränderte Darmflora hindeuten.
> Laktobazillen & Bifidobakterien – Diese probiotischen Bakterien sind wichtig für die Verdauung, Immunfunktion und den Schutz der Darmbarriere.
> Escherichia coli – Ein natürlicher Bestandteil des Darms, der bei Über- oder Unterbesiedlung problematisch sein kann.
> Clostridien & andere potenziell schädliche Keime – Manche Clostridien-Arten können toxische Stoffe produzieren und sollten in Balance mit anderen Bakterien stehen. - Verdauungsfunktion & Stoffwechselprodukte
> pH-Wert des Stuhls – Ein zu hoher oder zu niedriger pH-Wert kann auf Verdauungsstörungen oder ein Ungleichgewicht der Darmflora hindeuten.
> Kurzkettige Fettsäuren (Butyrat, Propionat, Acetat) – Diese Fettsäuren sind essenziell für die Darmgesundheit und dienen als Energiequelle für die Darmschleimhaut.
> Sekretorisches IgA – Ein wichtiger Marker für die Immunabwehr im Darm.
> Verdauungsrückstände – Zeigen, wie gut Nährstoffe im Darm aufgeschlossen und verwertet werden.
> Pankreas-Elastase – Funktion der Bauchspeicheldrüse und ihre Fähigkeit, Verdauungsenzyme zu produzieren.
> Gallensäuren – Deren Gleichgewicht ist wichtig für die Fettverdauung und Darmgesundheit. - Entzündungs- & Barrieremarker
> α-1-Antitrypsin – Ein Marker für eine gestörte Darmbarriere und entzündliche Prozesse.
> Calprotectin – Ein spezifischer Entzündungsmarker, der auf entzündliche Darmerkrankungen hinweisen kann.
> Zonulin – Gibt Hinweise auf eine gestörte Darmschleimhaut („Leaky Gut-Syndrom“).
> Sekretorisches IgA – Ein Marker für die Immunabwehr des Darms.
> EPX Protozoen (einzelligen Parasiten) – Hinweis auf allergische oder entzündliche Reaktionen im Darm z.B. bei Nahrungsmittelunverträglichkeiten - Pilze & Parasiten
> Candida & andere Hefepilze – Eine erhöhte Anzahl kann auf eine Pilzüberwucherung hindeuten, die Verdauungsprobleme und Blähungen verursachen kann.
> Parasiten, Protozoen (einzelligen Parasiten) & Wurmbefall – Werden durch spezielle Stuhluntersuchungen überprüft.
Diese Laborwerte helfen dabei, das Gleichgewicht des Darm-Mikrobioms zu beurteilen und gezielt Maßnahmen zur Verbesserung der Darmgesundheit zu ergreifen.

